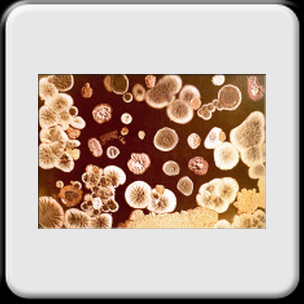

Perizie su matrici varie in relazione ad analisi eseguite o sullo stato di conservazione di prodotti alimentari, farmaceutici e/o d’erboristeria.
Consulenza tecnica nei vari procedimenti giudiziari.
Consulenza ed assistenza ad analisi di revisione presso l’Istituto Superiore di Sanità o presso ARPA varie.